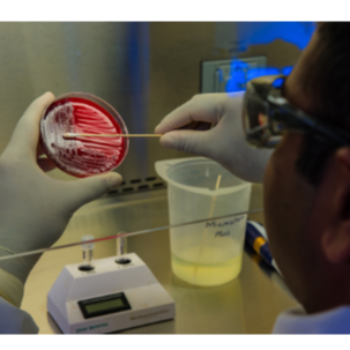
Unlocking Potential: How Microbiology Courses Empower Aspiring Scientists Indian Institute Ramway Plaza, Kharivav Rd, Dandia Bazar, Jambubet, Vadodara, Gujarat 390001

Products

Other Elementary Sub
The MLT program includes Laboratory Management, Time Management, Waste Management, Safety Management, Patient Care, Doctor Follow-up, Lab Software, Medico Legal, Physiology, and First Aid, focusing on efficient lab operations and patient care.
Read More

Blood Bank
MLT program includes ABO, RH blood grouping, donor screening, collection procedures, labelling, cross-matching, transfusion, and report preparation.
Read More

Body Fluids
The MLT program covers analysis of Urine, Stool, Semen, Sputum, Cerebrospinal Fluid, and Cavity Fluids. It includes the introduction to Pleural, Peritoneal, Pericardial, and Synovial fluids, focusing on diagnostic techniques and sample examination.
Read More

Microbiology
The MLT program covers Sterilization and its various methods, Bacteriology, Culture and Sensitivity Tests, Histopathology and Cytology preparation, and general special investigations of urine, stool, sputum, pus, semen, and gastric fluid, focusing on diagnostic techniques and sample analysis.
Read More

Bio-Chemistry
MLT program covers general and special biochemistry, including carbohydrate metabolism, lipid and cardiac profiles, renal and liver function tests, hormone studies, and coagulation profiles, focusing on laboratory techniques and analysis.
Read More

Hematology
The MLT program includes the study of syringes and needles, blood collection methods, anticoagulants, hemoglobin, total and differential counts, platelets, ESR, PCV, indices, reticulocytes, AEC, peripheral smear, anemia, and hematopoiesis.
Read More

Introduction
MLT - Medical Laboratory Technician program covers DMLT and PGDMLT focusing on Laboratory Ethics, Safety, Equipment, Matrix, Unit & Calculations, Care, and Personal Care.
Read More

Medical Lab Course T
Government certification for government job in DMLT or PGDMLT a Medical lab technology course at our training institute
Read More
Our Services
Number One In Gujarat, Providing Excellent Education And Excellent Placement
Being the top institution in Gujarat, it provides outstanding education and ensures excellent placement opportunities. Students benefit from quality academic programs and robust industry connections, preparing them well for successful careers.
Read More
30 Years Of Experience
With 30 years of experience, Indian institutes have refined their educational approach, combining traditional wisdom with modern innovations. They offer comprehensive learning environments that prioritize academic excellence, practical skills development, and holistic student support.
Read More
Bus Pass And Hostel Facility Is Also Available
Indian institutes offer bus passes for convenient commuting and hostel facilities for a conducive living environment, enhancing students' overall educational experience with convenience and comfort.
Read More
Seminar, Group Discussion And Scientific Programme Is An Excellent Way Of Learning
Indian institutes offer seminars, group discussions, and scientific programs for interactive learning. These initiatives build critical thinking, communication skills, and hands-on research experience, preparing individuals for academic and professional challenges effectively.
Read More
Can Open Own Laboratory
Graduates of the Indian Institute Service are equipped to open their own laboratories, supported by comprehensive training and practical skills. This readiness enables entrepreneurial ventures in various fields, ensuring innovation and professional success.
Read More
Latest Audio And Visual Facility
The Indian Institute Service features state-of-the-art audio and visual facilities, enhancing learning with immersive experiences. This technology ensures students receive comprehensive training and stay updated with industry standards, preparing them effectively for professional roles.
Read More
Camera Attached Microscope For Practical Training
The Indian Institute Service uses camera-attached microscopes for practical training, enhancing visualization and detailed analysis. This technology deepens understanding of microscopic techniques, preparing students for professional success.
Read More
Experience Staff With Latest Technology
The Indian Institute Service boasts experienced staff equipped with the latest technology, ensuring students receive top-tier education and training. This combination of expertise and advanced tools prepares students to excel in their fields and stay ahead in an ever-evolving job market.
Read More
Certificate Is Valid For Government Job And In CHC And PHC
The Indian Institute Service provides certifications valid for government jobs, including positions in Community Health Centers (CHC) and Primary Health Centers (PHC). This ensures that graduates meet the necessary qualifications and standards required for these essential public sector roles.
Read More
Hundred Percent Job Assistant
The Indian Institute Service guarantees 100% job assistance, ensuring every student receives personalized career support. With dedicated guidance, industry connections, and practical training, graduates are well-prepared and positioned to secure their desired employment opportunities.
Read More
Hundred Percent Practical Every Day
The Indian Institute Service offers a unique, hands-on educational experience with 100% practical training every day. This approach ensures students gain real-world skills and knowledge, preparing them effectively for professional success in their chosen fields.
Read More
Business Hours
Monday
Tuesday
Wednesday
Thursday
Friday
Saturday
Sunday